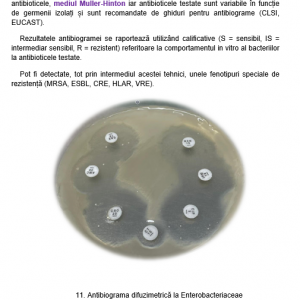

Activitățile prevăzute în planul de realizare al proiectului s-au desfășurat în perioada 1 ianuarie 2021 – 6 decembrie 2021, iar materialele dezvoltate în cadrul proiectului au urmărit fazele principale ale procesului educațional, respectiv predarea, asimilarea cunoștințelor și testarea.
- Configurarea unui server gazdă pentru resursele educaționale
- Proiectul Vizual-Life a beneficiat pe tot parcursul anului de sprijinul Departamentului IT al Universității Transilvania care au pus la dispoziția studenților de la Facultatea de Inginerie Electrică și Știința Calculatoarelor un server gazdă pe care s-a creat site-ul proiectului în vederea încărcării materialelor didactice create.
- Achiziția de echipamente ICT și software necesare
- S-au achiziționat echipamente/ materiale consumabile/reactivi/softuri cu ajutorul Departamentului de Achiziții al Universității Transilvania din Brașov.




- Achiziția de materiale consumabile și instrumente de laborator
- S-au achiziționat o serie de materiale consumabile cu ajutorul Departamentului de Achiziții al Universității Transilvania din Brașov.
- Creearea unui site de acces ierarhizat la resursele educaționale
- Pentru accesul la resursele educaționale create de echipa de lucru, studenții de la Facultatea de Inginerie Electrică și Știința Calculatoarelor au conceput și realizat o pagină web cu adresa https://vizual-life.unitbv.ro/




- Promovarea în rândul studenților a site-ului
- Ideea proiectului Vizual-Life, precum și site-ul au fost promovate pe tot parcursul desfășurării proiectului atât prin ajutorul cadrelor didactice implicate direct în coordonarea echipei, cât și de către studenții din proiect, în rândul colegilor de grupă, a colegilor de cameră și prietenilor.



- Proiectarea experimentelor de laborator
- Activități de proiectare a experimentelor de laborator s-au desfășurat pe tot parcursul proiectului, pe diferite tematici și sub atenta supraveghere a profesorilor coordonatori implicați în proiect.






- Colectarea de materiale didactice pe diverse tematici si prezentarea lor în format vizual sugestiv pentru etapele de predare/consolidare/evaluare
- În vederea realizării resurselor educaționale membrii echipei au colectat și studiat materialele didactice puse la dispoziție de coordonatorii disciplinelor prevăzute în propunerea de proiect, în vederea elaborării materialelor didactice teoretice, practice și de testare.

- Achizitia de imagine și film
- Achiziția de imagine și film s-a realizat cu o cameră video performantă împrumutată de la Facultatea de Litere, care a fost utilizată de către Badea Ștefania, Ciurchil Andreea, Marcu Ștefania și Stratu Carolina în laboratoarele Facultății de Medicină și a celei de Alimentație și Turism.


- Editarea foto și video
- Fișierele video și de imagine achiziționate cu ocazia desfășurării experimentelor de laborator au fost prelucrate utilizând aplicații software precum Blender, Vegas Pro, etc. Toate materialele realizate au fost verificate de către cadrele didactice coordonatoare.


- Realizarea de schițe animate, atlase, panouri digitale
- Materialele video cu experimentele științifice și animațiile pentru mecanisme realizate, precum și atlasul digital realizat vin în ajutorul studenților pentru suportul vizual al cunoștințelor despre diferite reacții, mecanisme, operații.

- Teste pilot pe grupuri de studenți pentru evaluarea eficienței materialelor didactice
- Obiectivarea creșterii capacității de transmitere a informațiilor către studenți s-a realizat prin teste pilot efectuate periodic pe parcursul anului universitar 2020-2021. Concluziile desprinse au fost foarte utile pentru îmbunătățirea proiectelor de laborator, a modalității de editare a fișierelor video, precum și a structurii testelor grilă.


- Definitivarea materialelor și încărcarea pe serverul educațional
- În urma observațiilor și a concluziilor desprinse după analiza testelor pilot, s-au definitivat materialele didactice teoretice, practice și de testare și au fost încărcate pe serverul educațional.
- Elaborarea de materiale online pentru aprofundarea cunoștințelor și abilităților studenților
- Utilizând resursele încărcate pe serverul educațional, s-au realizat peste 90 de materiale didactice pentru aprofundarea cunoștințelor și abilităților studenților.




- Întâlniri de monitorizare/diseminare internă a progresului proiectului
- Pentru coordonarea echipelor de lucru, pe parcursul derulării proiectului s-au realizat periodic întâlniri de monitorizare/diseminare internă a progresului proiectului.
- Diseminarea activităților și rezultatelor proiectului
- Au fost promovate de către studenții celor 3 facultăți implicate, conform planului de activități propus inițial.